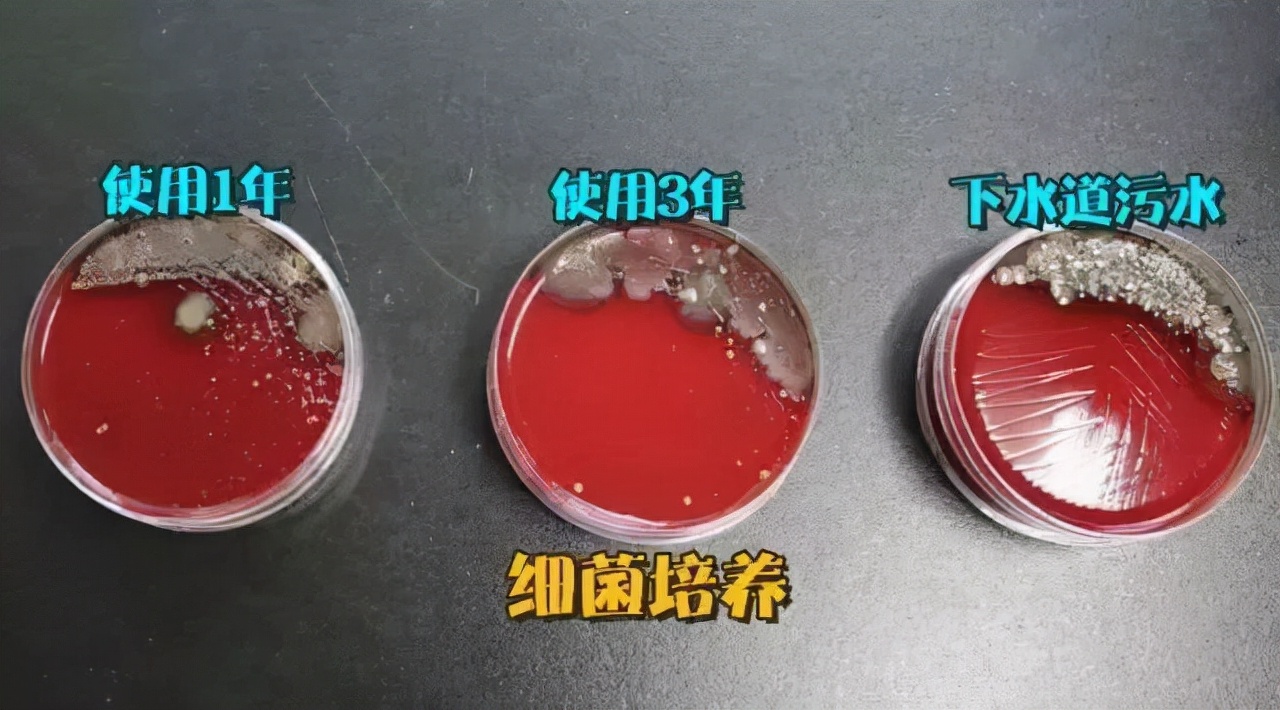
洗衣机不清洗究竟多脏？

家修汇 为您的家修保驾护航!
洗衣机,才是你家最脏的地方。

我知道你不解:洗衣机哪里脏?为什么会脏?洗衣服的时候不是把自己也洗干净了么?
上图为敬,这是拆开后的洗衣机:

作为家修行业的我们,对这样的情况已经是见怪不怪了,但是对于不知道如何清洗洗衣机的大家,洗衣机脏的有些触目惊心了!
这是你赖以生存,解放双手的洗衣机:

另一个事实是,2016年,上海市疾控中心抽样检查了128台使用半年以上的洗衣机,结果内槽霉菌检出率为60.2%,细菌总数检出率为81.3%,总大肠菌群检出率高达100%。
“上面这些是洗了多脏的东西,才能用成这样?”
别不信,拆开看看,说不定你家的比人家的还恐怖。
先搞清楚一件事: 洗衣机为什么会这么脏?
我们从洗衣机的结构和工作原理说起。
无论是波轮洗衣机,还是滚筒洗衣机,它们的工作原理是相通的:
通过旋转,让衣服和洗衣机的桶壁摩擦摩擦,带走污渍。

你有没有想过:衣服上的脏东西跑哪里去了?
这就和洗衣机的套筒结构有关了。
无论是波轮式还是滚筒式洗衣机,都有两个重要组成部分:
洗涤桶(内筒),盛水桶(外筒)。
洗衣桶负责和衣服接触摩擦,盛水桶用来装水。一个主内,一个主外,各司其职。

打开洗衣机,我们只能看到因为不断摩擦,呈现迷人光泽的内筒。
外面的塑料外桶, 你自然是看不到的。
而它们之间,有一个大约1~2公分的夹层,不会与衣物直接接触。这个密闭的空间,就是污垢温暖潮湿的藏匿处,以及菌类培养基地。

(拆开后的外筒壁)
而这些污垢、细菌,无外乎是来自自来水水垢、衣服纤维、衣服上的细菌、你的汗液……

你必须明白的一件事:除了“越洗越脏”, 不清洗的洗衣机还有什么危害?
2016年,上海市疾控中心抽样检查了128台使用半年以上的洗衣机,结果内槽霉菌检出率为60.2%,细菌总数检出率为81.3%,总大肠菌群检出率高达100%。
有人也自发做了个实验,将两台用了1年和3年的老式洗衣机上提取下来的污垢拿去做了检测。为了有一个直观的对比,又从下水道捞了不少污水一起送检。
实验室的检测结果是:
送检的洗衣机里的污垢,和下水道的脏水一样,滋生的细菌种类多、数量多。尤其是数量,已经多到无法计数。

大部分洗衣机使用坏境都比较潮湿,加上洗衣粉内的蛋白酶是微生物滋生的养分,因此加重了洗衣机的细菌繁殖。(没错,使用洗衣粉的洗衣机,会比使用洗衣液的更脏,而经常使用消毒剂的,内部则会有很多白色污垢。)
这些滋生的细菌、真菌不但会污染衣物,还会通过衣服二次污染,对妇女和小孩危害最大。
小孩子的一些皮肤病;姑娘们的霉菌性阴道炎;小伙子们的股癣体癣;
……可能都来自于洗衣机中的真菌。
即使经常使用清洗剂也并不能 100% 去除污垢,只能清洗掉大部分污垢!
洗衣机各个品牌的桶清洁功能程度参差不齐,完全看厂家的程序设计。而且限于目前洗衣机的构造,还有诸如波纹管、内筒支架后侧、外桶前侧这些位置并不能清洗到。

(使用了一年的洗衣机水管,必须拆机清洗)
如果你家洗衣机从买回来之后,从来没有清洗过,那么小编还是建议你:找专业的清洗师傅进行拆机清洗!!!
尤其是滚筒洗衣机,内部构造比较复杂,所以拆机需要一定的技术储备,没有经验的话不推荐自行拆机清洗。
尽量找专业的家政公司清洗~
视不同城市而言,清洗一次大概需要80-200不等,然后师傅会还原你一个崭新的洗衣机。

如果需要清洗洗衣机,请各大平台搜索“家修汇”。专业清洗,上门迅速,收费合理哦!
总结一下:
要想保持洗衣机的干净环境,一年可以联系专业师傅上门拆机清洗洗衣机一次,然后平时自己在家保证定时使用清洁剂清理,这样就能愉快地洗衣服了!
免责声明:部分图片素材来源于网络,仅供分享,如有侵权请联系删除。